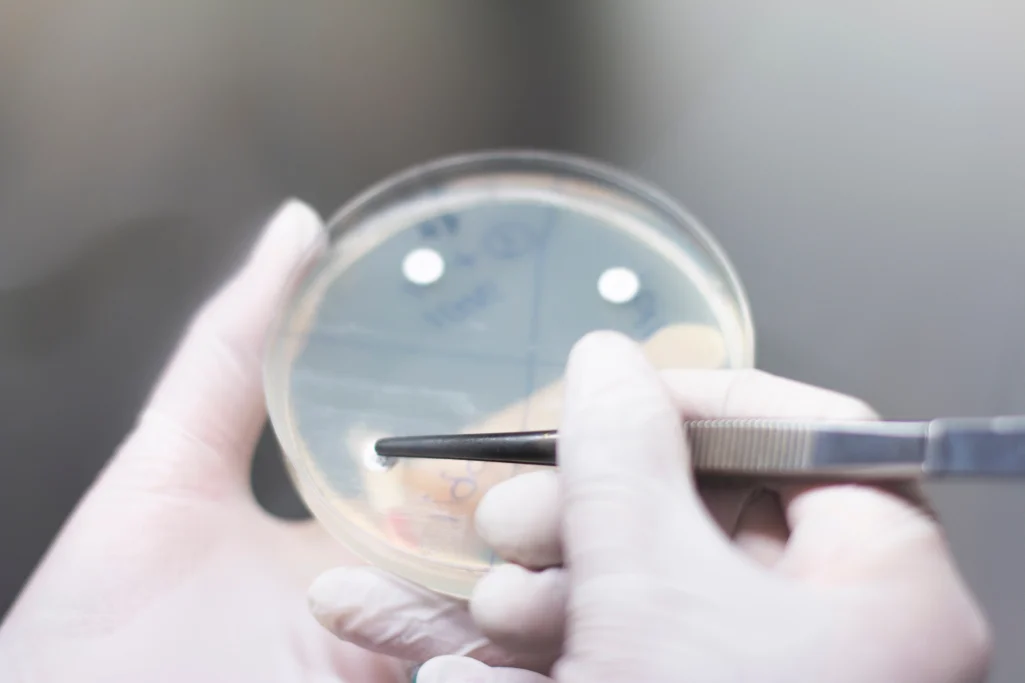

Subscribe
Follow us to stay updated on the latest advancements in innovative cancer therapies and OncoCube's progress. Get firsthand access to important information for your health!

OncoCube Therapeutics is a cutting-edge pharmaceutical company focused on revolutionizing cancer treatment. With our breakthrough TACC3 inhibitors, we are leading the way in targeted therapy for various cancer types. Our mission is to transform the landscape of cancer care by developing innovative and safe drugs with improved tumor-specificity. Join us in our journey to make a significant impact on global healthcare.
OncoCube Therapeutics develops innovative cancer therapies targeting Transforming acidic coiled-coil 3 (TACC3) in a broad range of cancers.

OncoCube has developed a series of drug candidates that exhibit a unique and validated mechanism of action towards TACC3 function in a wide range of cancers.
Our drug candidate utilizes a unique mechanism of action to reduce tumor growth by targeting a key protein localized to centrosomes and microtubules. Inhibiting TACC3 function has shown to cause spindle defects and mitotic catastrophe, leading to tumor regression in multiple tumor models with higher precision compared to existing treatments.
Follow us to stay updated on the latest advancements in innovative cancer therapies and OncoCube's progress. Get firsthand access to important information for your health!